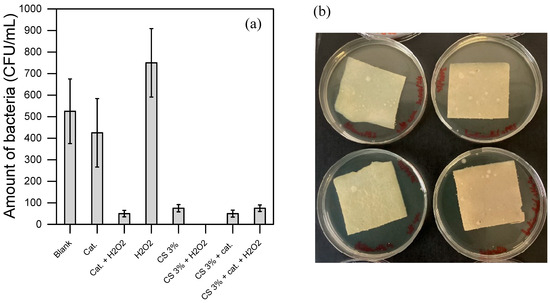

Abstract
This study explores chitosan (CS)-based materials for water purification, assessing their disinfection and contaminant degradation capabilities. A reproducible protocol was developed to fabricate homogeneous, stable CS films, validated through permeability testing and characterized using thermal (TGA), mechanical (tensile strength, elongation), and physico-chemical (FTIR-ATR, water contact angle, SEM-EDX) analyses. A catalyst was employed to complex iron ions and crosslink CS chains via acrylamide functions, stabilizing the CS structure and reducing washout in water. Disinfection tests showed that pure CS exhibited strong antimicrobial activity under varying contamination levels, attributed to direct contact and slight dissolution. Functionalized CS materials acted as catalytic surfaces, requiring hydrogen peroxide (H2O2) to generate reactive oxygen species (ROS). This ROS-mediated process effectively disinfected high bacteria loads and degraded phenol. Electron paramagnetic resonance (EPR) confirmed hydroxyl radicals as the primary active species when H2O2 was present. Under lower contamination levels, residual CS within the functionalized material contributed to direct antimicrobial effects, demonstrating a synergistic action between CS and ROS. These findings highlight CS as a reliable disinfectant and functionalized CS as a versatile material for ROS-driven antimicrobial action and contaminant degradation. The results suggest potential for scalable, sustainable water treatment applications. Future work will focus on optimizing the catalyst structure to enhance ROS production and improve contaminant removal efficiency.
1. Introduction
The water contamination crisis has become a pressing global issue, with chemical and biological pollutants increasingly affecting drinking water supplies, ecosystems, and public health [1,2]. Chemical organic contaminants, such as industrial byproducts (e.g., phenols) and pharmaceuticals (e.g., diclofenac), often persist in water sources due to their complex and stable molecular structures [2,3]. These pollutants not only endanger aquatic life but also accumulate in food chains, posing risks to human health [3,4]. Similarly, biological contaminants like bacteria, viruses, and harmful algal blooms contribute to disease outbreaks, especially in regions with limited water treatment infrastructure [5,6]. Together, these pollutants create a complex challenge that traditional water purification methods often struggle to address fully [7].
Physical separation methods such as adsorption (e.g., activated carbon) or membrane-based processes (e.g., nanofiltration, reverse osmosis), although effective in preventing the spread of organic pollutants in surface waters, do not permanently eliminate them. Consequently, these approaches fail to prevent the long-term accumulation of contaminants in the environment, the true concern associated with chemical pollution, as they merely concentrate the pollutants in a different location rather than destroying them. Advanced Oxidation Processes (AOPs) have emerged as a powerful solution in the fight against water contamination. AOPs leverage reactive species, primarily hydroxyl radicals, to break down organic pollutants that resist conventional treatment methods into less harmful or fully mineralized substances [8,9]. AOPs can be implemented through various techniques, including photocatalysis, ozonation, and Fenton reactions, each tailored to target specific contaminants [10,11,12]. The versatility of AOPs allows for the treatment of both chemical and biological pollutants, providing an efficient approach to water purification [11,13,14]. However, many AOPs, such as photocatalysis, UV-based oxidation, and ozonation, require significant energy input to generate reactive radicals, leading to high operational costs [8,9,15]. This energy demand can be a barrier, especially in low-resource areas or large-scale applications where cost-effectiveness is crucial [16]. Also, some AOPs involve sophisticated equipment or precise control of operating conditions (e.g., pH, temperature, light intensity), and this complexity requires specialized personnel for operation and maintenance, adding to the overall cost and limiting the viability of the processes.
Chitosan-based materials, like other biopolymers, have gained considerable attention in water treatment applications due to their exceptional properties, such as biocompatibility and biodegradability [17,18,19,20]. Derived from chitin, a natural polysaccharide found in the shells of crustaceans, chitosan (CS) could be easily recycled from seafood wastes, allowing its sustainable implementation [21,22]. CS also exhibits antimicrobial properties, making it an effective material for inhibiting the growth of bacteria, fungi, and some viruses [23,24]. The integration of chitosan-based materials with AOPs holds great promise for tackling simultaneously both chemical and biological contamination in water, limiting energy demand and environmental impact of the starting materials and the process.
CS is widely recognized for its ability to complex with metals, a property utilized in various studies to catalyze the degradation of toxic contaminants [25,26,27,28,29]. However, expensive or toxic metals are often used [26,27,29,30]. Farinelli et al. demonstrated the catalytic efficiency of a dissolved CS-iron complex at near-neutral pH, which successfully avoids the drawbacks of traditional Fenton reactions, such as extensive pH adjustments and large sludge production to dispose of [28]. While this system uses safe and accessible materials, it still requires frequent replenishment of the soluble catalyst, resulting in high chemical consumption.
Developing CS-iron films could overcome this limitation in the direction of a stable, reusable catalyst. Literature shows some examples of chitosan-based materials generally employing rare earth, toxic, or expensive metals (e.g., bismuth, molybdenum, cobalt, copper, etc.) to promote catalysis [31,32]. This approach, despite promising, is not sustainable, and it is in contrast with the choice of a cheap, accessible, and biocompatible backbone as chitosan. Instead, the use of cheap, accessible, and non-toxic elements, such as iron, can offer the right resonance with a novel and biocompatible approach, using a chitosan–metal system to degrade contaminants. However, as Farinelli et al. also noted, the CS-iron complex in film form is highly soluble in water, compromising its stability, despite resulting in efficient degradation of contaminants [28]. Therefore, it is required to increase the stability of the material in water.
Crosslinking CS chains improves water stability by creating a more robust structure [33,34]. Nevertheless, this approach will limit metal-complexing capacity, as the binding sites become occupied by crosslinkers.
Extensive research exists on iron complexes that both activate hydrogen peroxide for contaminant degradation and stabilize iron in solution [35,36]. By binding such complexes to CS, a stabilized CS structure with accessible iron-binding sites could be achieved. However, these complexes are typically not designed to crosslink CS directly, highlighting the need for tailored complexes that can both stabilize and integrate effectively into the CS matrix.
In contrast, this study introduces a novel design concept by developing an iron-based complex specifically tailored to simultaneously crosslink and functionalize CS, promoting its catalytic activity. The synthesized complex reacts with the primary amine groups of CS, enabling covalent integration into the polymer backbone while preserving and enhancing its iron-binding and catalytic functionalities. This dual-function approach addresses the longstanding trade-off between structural stability and metal accessibility, leading to a CS-based material with improved durability, catalytic efficiency, and reusability for water treatment applications. All this was achieved without rare earth, toxic, or expensive metals, but using only accessible elements, such as iron, and with an easy-to-make organic ligand.
This work provides a comprehensive characterization of the pure CS material and its functionalized form with the tailored iron complex, including their thermal, mechanical, and water stability, as well as their chemical composition and morphology. The applicability and efficiency in water of the obtained materials were tested toward phenol (PhOH) degradation and E. coli disinfection. The newly functionalized material confirms the hypothesis that it can work as a catalyst, able to both degrade contaminants and disinfect by generating hydroxyl radicals. The active species involved in the process were evaluated through electron paramagnetic resonance. Conversely, the pure CS film confirms its antimicrobial activity, but as expected, it is not able to act as an effective catalyst to degrade contaminants.
The study concludes that the CS-AOP synergy, which degrades contaminants and displays disinfection activity, not only improves the overall versatility of a water treatment process but also offers a more eco-friendly and viable solution. CS-based materials, which contain complex iron ions, are natural and renewable, with minimal environmental impact.
2. Materials and Methods
2.1. Chemicals
Chitosan (CS) was supplied as flakes by France Chitine (Batch type 342 from shrimp shells). The sample had a viscosity of 100 cP at 25 °C (producer data) with a mass average molecular weight of 180,000 g·mol−1 and a degree of acetylation of about 20%. All the other compounds used in this study were purchased from Sigma-Aldrich (Saint-Quentin-Fallavier, France) and Tokyo Chemical Industries (TCI, Tokyo, Japan).
2.2. Catalyst Synthesis
The iron-phenanthroline complex (Figure S1a) was prepared in situ in water in a stock solution of 0.01 M dosing Phenanthroline and FeSO4·7H2O in a ratio of 3:1. Aliquots of this stock solution were taken to perform the oxidation reactions.
The synthesis of the functionalized complex (Figure S1b) followed the procedure of Pirkin-Benameur [37]. From 0.7 M stock solutions of phen and phen-5-yl-acrylamide in CH2Cl2, a 2:1 mixture of phen: phen-5-yl-acrylamide (12 mL/6 mL) was made. The solution was evaporated to dryness, and the stoichiometry was controlled by 1H NMR in DMSO-d6.
In a Schlenk tube, FeSO4·7H2O (1.357 g, 4.88 mmol) was dissolved in 5 mL of water and degassed under argon. The previous mixture of phen (9.76 mmol) and phen-5-yl-acrylamide (4.88 mmol) was added as a solid, and the dark red solution was stirred overnight under argon. NH4PF6 (1.591 g, 9.76 mmol) in water (5 mL) was added, leading to the precipitation of the complex. The mixture was stirred for 20 min before filtering the complex. The solid was washed with cold water (3 × 5 mL) and diethyl ether (3 × 5 mL) and dried under vacuum (3.6 g, 73%).
1H NMR (CD3CN, 360 MHz, 300 K) δ (ppm): 9.01 (s, 1H, (C=O)NH), 8.73 (m, 2H, Harom), 8.61 (m, 4H, Harom), 8.56 (dd, J = 7.9 Hz, J′ = 1.6 Hz, 1H, Harom), 8.26 (s, 4H, Harom), 7.62 (m, 12H, Harom), 7.62 (m, 12H, Harom), 6.67 (dd, J = 17 Hz, J′ = 11 Hz, 1 H, Hacrylamide), 6.48 (dd, J = 17 Hz, J″ = 1.6 Hz, 1 H, Hacrylamide), 5.92 (dd, J′ = 11 Hz, J″ = 1.6 Hz, 1 H, Hacrylamide).
ESI-MS: m/z = 367.0904 (calcd for (phen*)2(phen)Fe2+ 367.0920, error = 4 ppm), 332.5801 (calcd for (phen)2(phen*)Fe2+ 332.5813, error = 3.6 ppm). Phen stands for 1,10-phenanthroline and phen* for 1,10-phenanthrolin-5-yl-acrylamide.
Electrochemistry: reversible FeIII/II couple at E1/2 = 1.1 V (ΔE = 100 mV) vs. SCE.
UV-vis (MeCN, 300 K): λmax = 435 nm (MLCT, ε = 14,400 L·mol−1·cm−1) and λmax = 510 nm (MLCT, ε = 17,500 L·mol−1·cm−1), λmax = 265 nm (π−π*, ε = 124,000 L·mol−1·cm−1).
2.3. Chitosan Film Preparation
CS solutions were obtained by dissolving CS powder in diluted acetic acid solution (0.1 M) to achieve stoichiometric protonation of the amine moieties according to the following chemical reaction:
where CS-NH2 and AcOH are the free amine form of chitosan and the undissociated acetic acid form, respectively. CS-NH3+ represents the protonated form of chitosan, soluble in water and AcO− the acetate counter ion. In the same mixture was added 3% (w/v, where w/v = g of solute in 100 mL of solution) of polyethylene glycol (PEG) to increase the flexibility of the final material. Two solutions of CS were prepared at concentrations of 3% and 4% (w/v). Below 3% (w/v), the mechanical properties of prepared materials were not sufficient for handling the samples in a durable way in water, and higher concentrations gave final solutions too viscous to obtain a homogeneous casting. The CS mixtures were stirred at room temperature until the solution looked transparent and homogeneous. All the air bubbles were removed with a water vacuum pump until no more bubbles were observed in the solution.
CS-NH2 + AcOH ↔ CS-NH3+ + AcO−
CS-based mixtures were cast on a glass plate with a 1.5 mm gap casting knife using an automatic coater (K Control coater, Erichsen, Iserlohn, Germany). The cast film was dried at room temperature to partially evaporate the solvents. Subsequently, the materials were neutralized by immersing them in a 1 M NaOH solution. Treating the composite with NaOH was found to significantly improve the composite’s resistance to water washout. After 24 h immersion duration, the obtained white materials were thoroughly rinsed with deionized water to remove the excess NaOH and reach a neutral pH value. The materials were then stored in deionized water.
2.4. Functionalized Film Preparation
The CS films were dipped and stirred at room temperature for 24 h in a 1 mM catalyst solution with acrylamide functions to donate a bright red film. The materials were then stored in deionized water.
2.5. Materials Characterizations
2.5.1. Infrared Spectra Measurements
Infrared spectra of composite materials were recorded using a Nicolet Nexus Fourier-transform infrared (FTIR) spectrometer with attenuated total reflection (ATR) from Thermo-Fisher (Villebon sur Yvette, France). The spectra were acquired in the wavenumber range from 2000 to 700 cm−1 with 64 scans at a 4 cm−1 resolution. Samples for FTIR analysis were dried overnight at 60 °C and afterwards kept under vacuum in a lyophilizer for 3 h to remove all possible water traces. The baseline was adjusted directly by the software of the instrument.
2.5.2. UV-Visible Analysis
UV-Vis spectrophotometric measurements were performed using a UV-2401-PC from Shimadzu (Kyoto, Japan).
2.5.3. Chromatographic Analysis
The concentrations of PhOH in solution were monitored by ultra-high-performance liquid chromatography, with UV-Vis detection (UHPLC-UV). The used UHPLC U3000 (Thermo-Fisher) was equipped with an Autosampler (injection volume 7 µL), a quaternary pump for low-pressure gradients, and a column oven (set at 25 °C). The column was a Kinetex C18-100A (length 100 mm, diameter 2.1 mm—particle size 1.7 μm EVO). Elution of contaminants was carried out in gradient mode, with a mixture of A = water + 0.1% formic acid, and B = acetonitrile + 0.1% formic acid, at a flow rate of 0.5 mL min−1. The gradient was: time (t) = 0 min 100% of A—0% of B; t = 1.5 min 70% of A—30% of B; t = 2.0 min 0% of A—100% of B; t = 4.0 min 0% of A—100% of B; t = 4.1 min 100% of A—0% of B; t = 5.0 min 100% of A—0% of B. The PhOH was analyzed at λ = 270 nm, where λ = detection wavelength.
2.5.4. Thermal Stability Analysis
Thermogravimetric analysis (TGA) was carried out using the Thermal Analysis SDT 2960 Simultaneous TGA-DTA analyzer of TA Instruments (New Castle, DE, USA) in the temperature range of 20–1000 °C at a heating gradient of 5 °C/min in nitrogen.
2.5.5. Material Morphology Observation
The surface and cross-section morphology of the obtained materials were observed by Scanning Electron Microscopy (SEM) (Hitachi S-4500, resolution of 1.5 nm at 15 kV, Hitachi High-Tech Corporation, Tokyo, Japan). The samples were dried at room temperature, cut into small pieces, and then covered with a thin layer of platinum (Pt) by sputter coating before SEM analysis.
2.5.6. Mechanical Property Measurements
The tensile rupture and the elongation percentage of the materials were analyzed by the Zwick/Roell 7005 traction machine. The sample of 2.5 cm2 was fixed between 2 grips. The distance between the two grips was 2 cm, and 5 samples were tested for each material. The temperature was controlled at 25 °C thanks to a CTD180 Peltier system. This test was performed on the material in the wet state. The wet state corresponds to a material being stored in water for more than 24 h.
2.5.7. Water Contact Angle
Water contact angle (WCA) measurement is the most effective method to follow the change in hydrophilicity and the wettability of the material surface. WCA was determined by the sessile drop method with an instrument provided by GBX Ltd. (Romans-sur-Isère, France). A 10 μL droplet of distilled water was deposited onto the material surface by means of a 50 μL syringe. The drop contour and the contact angle were analyzed using the software of the instrument. Measurements were carried out 10 times, and the average values are reported.
2.5.8. Filtration Tests
Frontal filtration experiments were carried out on CS 3% films using a stirred dead-end cell (Amicon 8050, Millipore Corporation, Guyancourt, France) with materials having an active surface area of 2.5 cm2. The samples of the CS 3% material were taken from different areas of the same sheet (10 × 20 cm2). The materials were first compacted by filtering pure water at 3 bar until a constant flux was observed. Pure water flux (Jpw) was measured for each material by circulating deionized water through the material system using an applied pressure of 2 bar. Jpw (l h−1 m−2) was calculated using the following formula:
where Q (l) is the amount of water collected, Δt (h) is the time duration using a material of surface area A (m2).
2.6. Oxidation Protocol
The oxidation tests with the dissolved catalyst (Figure S1a) were performed with a relative concentration ratio catalyst: contaminant: oxidant equal to 1:1:4. The concentration of catalyst is intended as that of the central ion. More precisely, the oxidant was sequentially added in four successive steps (1/4 of the total concentration each time) at time zero and then every 5 min. The final reaction time for all the oxidation experiments was 20 min. All reactions occurred in 10 mM Phosphate-Buffer Solution (PBS, pH 6) at room temperature under atmospheric pressure and magnetic stirring. These conditions were chosen according to previous studies employing similar systems [28,38].
The CS and CS functionalized films obtained as described above were placed in contact with a 0.1 mM solution of the target contaminant, PhOH. The oxidant was added in four aliquots as previously described, reaching a ratio of contaminant: oxidant equal to 1:4 in 20 min. The reactions were conducted in 10 mM PBS for 20 min at room temperature and atmospheric pressure, at near-neutral pH (pH 6), under slow magnetic stirring.
To rule out the possibility of PhOH adsorption onto the materials, these films were placed in contact with a PhOH solution for 20 min before starting the oxidation. No differences from the PhOH starting concentration were detected after this time, hence no adsorption occurred in this condition.
2.7. Materials, Bacterial Culture and Suspension
An E. coli (strain K12 from DSMZ, Braunschweig, Germany) was used for the disinfection tests. For the culture, a ready-to-use Lysogeny Broth (LB) Miller (from Sigma-Aldrich, France) was used as a nutrient-rich culture medium. LB was prepared at 25 g/L in deionized water. For bacteria enumeration, sterile LB agar plates were prepared with a nutrient agar obtained by mixing 25 g/L LB and 15 g/L microbiologic agar (from Sigma, France) in deionized water. Additionally, soft agar solution containing nutrient agar with reduced agar content (i.e., 5 g/L agar vs. 15 g/L) was prepared. The soft agar was maintained at 40 °C until its use for solid tests with the CS materials. Bacteria dilution was carried out in a 12.9 mM PBS at pH 6.0, whose composition was 1.06 g/L KH2PO4, 4.34 g/L Na2HPO4·12H2O. PB was also used to wash the chitosan (CS) materials and carry out serial dilutions for the counting of the bacterial samples taken during the experiments (Section 2.8). Before use, all the solutions were sterilized by autoclaving (20 min at 121 °C) or filtration through a 0.22 µm PES filter. All the CS materials tested were sterilized under UV for 20 min per side.
To prepare the bacterial cultures, frozen aliquots of E. coli were quickly thawed at room temperature before being transferred at 4% v/v into sterile LB. The Erlenmeyer culture flasks were closed with air-permeable caps to prevent contamination. They were then placed overnight in a shaking incubator set to 30 °C and 200 rpm, until the stationary growth phase was reached. The concentration of bacteria was measured by Optical Density at 600 nm (OD600). The obtained bacterial concentration was around 109 CFU/mL (Colony Forming Unit/mL). A correlation between OD600nm and cultivable cell concentration was previously established in the herein conditions [39].
At the end of the cultivation step, E. coli suspensions were prepared. The bacterial culture previously obtained was centrifuged at 4000 rpm for 12 min at 4 °C, to collect the bacteria at the bottom of the tube. The LB supernatant was carefully discarded, and the resulting bacterial pellet was resuspended in the same volume of PBS. PBS was chosen to maintain the bacteria in a resting-cell state (i.e., non-proliferating state) and at a constant concentration, as it does not contain nutrients to support bacterial growth. Finally, the resting bacterial suspension was diluted in PBS to reach an approximate final concentration of 50 CFU/mL and implemented for the disinfection trials. The concentration of the suspension was enumerated before use (Section 2.8).
In one case, the bacterial culture was not centrifuged and resuspended in PBS. The stationary culture was directly diluted in PBS to reach the desired cell concentration for the disinfection experiment (i.e., 50 CFU/mL). Nutrient residues from the LB were hence still present in the final bacterial suspension. This assay was intended to mimic more realistic matrices favorable to bacterial proliferation, as can be found in water treatment systems.
2.8. Disinfection Protocols and Bacterial Counting
For the tests, 10 mL of the bacterial suspension (at an initial concentration of 50 ± 20 CFU/mL) was sterilely introduced into a Petri dish containing the sterilized CS materials, in the presence or absence of H2O2. Controls were also carried out without materials, i.e., with the bacterial suspension or with the bacterial suspension mixed with the free soluble catalyst (Cat) at the same quantity as the one grafted in the functionalized CS materials (0.1 mM). As for the tests with the CS materials, controls were implemented with and without H2O2. The control in the bacterial suspension without H2O2 was named “Blank”, whereas the control with both bacterial suspension and H2O2 was denominated “H2O2”. In all cases, H2O2 addition was carried out at the beginning of the assays by adding a small volume (200 µL) of a concentrated H2O2 solution (at 10 mM) in the bacterial suspension; when no H2O2 was added, a similar volume of PBS was added instead.
The Petri dishes were then incubated for 3 h at 30 °C. At the end of the incubation, two types of characterizations were performed as follows:
- Assessment of the bacteria adsorbed onto the materials: The CS materials were first separated from the bacterial suspension and transferred to an empty Petri dish using a sterile clamp positioned around the sample ends (not to touch the material surface). The soft agar solution was then poured directly into Petri dishes over the tested material to grow the remaining cultivable bacteria adsorbed to its surface. The softer consistency of the soft agar was chosen to allow oxygen diffusion across the agar layer, as oxygen is vital for E. coli to proliferate. This soft agar also allows the remaining cultivable bacteria to migrate through the nutritive gel and reach the surface following the oxygen gradient.
- Enumeration of the bacteria in suspension: Samples of the bacterial suspension incubated at different disinfecting conditions were enumerated according to the conventional plaque assay method [39]. In that frame, samples that were undiluted and diluted by a factor of ten in PBS were spread (400 µL) onto standard LB agar plates (400 µL per sample and LB plate) and incubated at 30 °C for 48 h. Each count was triplicated.
3. Results and Discussion
3.1. Chitosan Films
Chitosan is a promising starting material to produce novel catalytic materials. However, its features should be adapted to water treatment in the herein study. The ideal base material must be homogeneous and water-stable to facilitate surface functionalization for water treatment applications. The free amine of chitosan can be an accessible site to allow the aza-Michael addition of a customized catalyst [40,41]. In this respect, the amine group of chitosan has to be deprotonated. A pure chitosan material was then prepared and neutralized with a 1 M solution of NaOH as detailed in the Methods and Materials (M&M) section. Figure 1a shows the resulting pure chitosan material, which appears white and visually homogeneous. In contrast, Figure 1b presents the functionalized material with the iron-based catalyst, exhibiting a distinct color change to red, indicating successful material functionalization.

Figure 1.
Illustration of the prepared films. Specifically, (a) CS 3% and (b) CS 3% cat.
However, only a minimal amount of catalyst is bound to the chitosan; starting from a 1 mM catalyst solution in water, only 0.1 mM effectively bound to the material (see Figure S2), hence the concentration of catalyst on the surface is 0.001 mmol/2.5 cm2. This suggests that multiple amine groups of the CS structure may be associated with a single catalytic core, limiting the material’s surface accessibility for additional catalyst binding. Indeed, the catalytic core exists as a distribution with 0, 1, 2, or 3 acrylamide groups in the catalyst structure that likely contribute to material crosslinking, further stabilizing the material [37].
3.2. Materials Characterization
Figure 2a displays the FTIR-ATR spectra of pure CS or functionalized CS films at two concentrations, respectively, 3% and 4% of CS, or CS 3% cat. and CS 4% cat. In the spectra of pure CS, the amide I band is observed around 1650 cm−1, corresponding to C=O stretching in potentially residual acetylated units within chitosan. The peak near 1580 cm−1, attributed to N–H bending, confirms the presence of amino groups in the chitosan structure. Peaks between 1020 and 1150 cm−1 represent C–O stretching and C–O–C bending vibrations of glycosidic linkages in the chitosan backbone [42]. Notably, there are no significant differences in the spectra between 3% and 4% CS films, and all the peaks identified align with literature data [43,44].

Figure 2.
(a) Infrared spectra in ATR mode, (b) thermal gravimetric analysis, (c) water contact angle, and (d) mechanical features: rupture strength (left y-axis, gray bars), percentage of elongation (right y-axis, white bars) of CS 3 and 4% and their functionalized version (CS 3% cat. and CS 4% cat.).
On the other hand, the spectra of functionalized CS films present an inversion in the C=O/N–H peak ratio, favoring C=O. This shift suggests a reduced bending energy of N–H, indicating alterations likely due to functionalization by an aza-Michael addition. Additionally, a more pronounced peak at 1420 cm−1 appears in the spectrum of functionalized CS, associated with C=C double bonds in the catalyst structure. This feature supports a covalent bond between the amine group of chitosan and the acrylamide in the catalyst, confirming the catalyst’s presence in the functionalized chitosan material.
The TGA results presented in Figure 2b clearly indicate enhanced thermal resistance in the functionalized CS materials. Specifically, the functionalized materials exhibit a secondary decomposition onset at approximately 750 °C, compared to 500 °C for pure CS. This shift implies a significant increase in thermal resistance of the glycosidic backbone, likely attributed to crosslinking introduced during functionalization. Crosslinking usually stabilizes the structure, requiring more energy to break down the polymer matrix, which delays decomposition and enhances the material’s overall thermal stability. Indeed, the most significant weight loss occurred between 250 and 500 °C in pure CS and between 250 and 750 °C in functionalized materials. This primary decomposition stage is attributed to the degradation of the chitosan polymer backbone, specifically the breakdown of glycosidic linkages. During this phase, depolymerization and decomposition of chitosan’s saccharide rings occur, leading to the release of volatile compounds, such as CO, CO2, and other gases [42]. The first weight loss occurs at temperatures below 100 °C in all the materials and corresponds to the evaporation of absorbed water. Chitosan, being hydrophilic, tends to retain water molecules, which are gradually released upon heating.
A smaller weight loss is observed after 500 °C and 750 °C for pure CS and functionalized CS, respectively. It is attributed to the further breakdown of residual carbonaceous material [42]. This stage involves the degradation of any remaining organic fragments and leads to the formation of char. Higher thermal stability highlights the effectiveness of the functionalization process, making it potentially more robust for applications.
The contact angle of pure CS and functionalized chitosan with organic molecules provides insights into the surface hydrophilicity or hydrophobicity of the material, which is crucial for applications in water treatment and surface interactions. Figure 2c illustrates the hyper-hydrophilicity of the prepared pure CS films, indicating a contact angle of approximately 20° in both 3% and 4% CS. This hydrophilicity is attributed to the presence of hydroxyl (-OH) and amine (-NH2) groups on the chitosan surface, which readily interact with water molecules. Conversely, when CS is functionalized with the catalyst, the contact angle increases above 80°, hence the material becomes more hydrophobic. This is consistent with the hypothesis of crosslinking induced by the catalyst and the hydrophobic nature of the latter. This is because the non-polar groups of the catalyst and a higher crosslinking reduce surface energy, making the surface more hydrophobic. This change in contact angle upon functionalization demonstrates a modification in surface properties.
The mechanical characterization results in Figure 2d provide valuable insights into the tensile properties and elasticity of the CS and functionalized CS materials. The tensile strength (shown on the left y-axis) and the percentage of elongation (shown on the right y-axis) indicate the material’s mechanical robustness and flexibility, respectively. All materials were conditioned at 25 °C prior to testing for consistency. The data reveal that both tensile strength and elongation follow a similar trend among the materials, with functionalized materials exhibiting lower values in both metrics compared to pure CS films. This decrease in tensile strength and elongation is consistent with the hypothesis that crosslinking within the functionalized material structure enhances rigidity but compromises flexibility, resulting in a more brittle material.
Despite the reduced elasticity, the functionalized material demonstrated notable stability in washout tests. Unlike pure CS films, which partially dissolved within one hour of immersion (see Figure S3), the functionalized material remained stable. This enhanced stability suggests that the crosslinked structure in the functionalized material resists dissolution, making it a promising candidate for repeated use in water treatment applications where durability and chemical stability are required. The consistent behavior of the 3% and 4% CS films, as shown in Figure 2, suggests that the chemical, thermal, and mechanical properties of the material are not significantly influenced by the slight variation in CS concentration. Figure S4a allows visualization of the FTIR spectrum of the sole catalyst, while Figure S4b demonstrates that the enhanced thermal stability of the material is not an intrinsic property of the added catalyst, since it occurs at 300 °C. Given this similarity, the 3% CS film was selected for subsequent experiments to optimize resource use without compromising performance.
3.3. Morphology and Composition Chitosan Layer
All the prepared materials show a relatively smooth, uniform, and continuous surface morphology under Scanning Electron Microscopy (SEM), as illustrated in Figure 3. The 4% CS film appears slightly rougher than the 3% CS film, potentially due to partial insolubility of CS at higher concentrations in the casting solution. This slight roughness could be a result of incomplete dispersion or aggregation of chitosan chains when more concentrated, leading to small surface irregularities. It is important to note that the SEM images were taken on dry films, so the observed morphology may differ from the material’s microscopic structure in water. In aqueous environments, chitosan films swell and adopt a more hydrated and porous structure, which influences their functional properties, such as permeability. Therefore, while SEM provides valuable insights into the film’s dry-state morphology, additional characterization in hydrated conditions would be useful to fully understand the material’s behavior in applications in water treatments. The EDX spectrum of pure chitosan shows peaks corresponding to carbon (C), oxygen (O), and nitrogen (N), which are the primary elements in the chitosan polymer (Figure 3a,b). The nitrogen peak arises from the amine groups in chitosan, confirming its composition. On the other hand, additional signals corresponding to iron (Fe) were detected in the functionalized film, confirming the presence of the iron-based catalyst bound to the material surface (Figure 3c,d).


Figure 3.
SEM-EDX analysis of (a) CS 3%; (b) CS 4%; (c) CS 3% cat.; (d) CS 4% cat.
3.4. Stability of Chitosan’s Film
The homogeneity and the stability of the chitosan sheet were assessed through permeability tests performed on various sections of the material. This evaluation was essential to confirm the reliability of the preparation protocol and to ensure that the chitosan sheet displayed consistent properties across its entire surface. The results of these tests demonstrated a low permeability for the pure chitosan, as shown in Figure 4, which is indicative of the strong interactions between glycosidic chains. These interactions align with the dense morphology observed in the dry material, as illustrated in Figure 3a.


Figure 4.
Flux of different sections of the same sheet of a pure CS film.
Each test was conducted on randomly cut 2.5 cm2 sections from a 3% pure chitosan sheet measuring 10 × 20 cm. The average permeability was around 20 LMH/bar, with a stable flux maintained over a 2 h testing period under a constant pressure of 2 bar. This stability in permeability and flux highlights the robustness of the chitosan sheet, showing that the material can withstand sustained pressure without altering its permeability characteristics.
Overall, these findings strongly affirm both the reproducibility of the preparation protocol and the structural stability of the chitosan sheet. This stable performance underscores the material’s potential suitability for applications in water treatment.
3.5. Activity of the Novel Material Toward Degradation of Contaminants
This work not only focuses on establishing a sustainable and reproducible method for fabricating stable materials in aqueous environments, but also aims to explore their practical application in water purification. To evaluate this, an iron-based catalyst, pure CS, and functionalized chitosan were tested for their ability to catalyze PhOH degradation, which was used as a model contaminant (see Figure 5a). As expected, pure chitosan alone was unable to catalyze the reaction between H2O2 and PhOH, showing no activity in this context. However, the iron-based catalyst and the functionalized chitosan material exhibited an activity towards PhOH degradation. The optimal degradation efficiency occurred at pH 6 in both cases, consistent with results from previous studies involving similar systems [38,45]. This catalytic activity supports the hypothesis that the reaction may generate transient oxidative species, which facilitates the degradation process.

Figure 5.
(a) Degradation percentage of PhOH. The reactions were performed at different pH levels in 20 min in the presence of PBS 10 mM, PhOH 0.1 mM, 0.1 mM of the dissolved iron-based catalyst (Cat. pH 6), or 2.5 cm2 of pure CS (CS 3%), and the catalytic material (CS 3% cat.) was used as a catalyst. H2O2 was dosed through 4 stepwise additions of 0.1 mM, each 5 min. The experiments were tripled. (b) EPR spectrum of the radical transient species during the oxidation (conditions: PBS 10 mM, PhOH 0.1 mM, 0.1 mM of the dissolved iron-based catalyst). H2O2 was added once in the reaction system at 0.4 mM. DMPO 17 mM was used as a spin trap, and the spectra were taken after 5 and 20 min of reaction. The results suggest that the active species is ●OH. The reaction took place between H2O2 and PhOH in the presence of the dissolved catalytic core without the acrylamide functions. The ticks in the figure aim only to help the reading of the peaks.
EPR measurements led to the detection of the active species involved. The reaction was carried out in the presence of a spin trap to detect potential radical species released in solution and analyzed by EPR. The system clearly shows an adduct with DMPO, hence the presence of a radical species. The parameters of the simulation were as follows: aN = 14.9 Gauss; aH = 14.9 Gauss; g = 2.0057 (correlation coefficient = 0.9995), in agreement with literature data for the DMPO-●OH adduct, hence the detected radical species is ●OH that is immediately formed [46]. The reference peak shows very low intensity, which likely indicates minimal generation of hydroxyl radicals, a factor that could explain the catalyst’s limited effectiveness in degrading phenol. The reaction was repeated with the same materials 3 times, providing an acceptable standard deviation (>5%), thus implying that the catalytic sites remained stable during the reactions. This suggests that either the chitosan backbone may scavenge hydroxyl radicals during the reaction or the catalytically active core designed is not efficient enough. To enhance contaminant oxidation in water, more efficient catalysts would need to be developed. As for the reaction conditions, the PBS used in this study should not impact the reaction’s efficiency, as previous studies have shown successful radical reactions under similar conditions. Despite the current limitations, these findings demonstrate that the material can generate ROS capable of degrading toxic contaminants, highlighting a promising foundation for further development of this concept.
3.6. Activity of the Novel Material Toward Disinfection
In water purification, effective applicability typically requires both the degradation of toxic contaminants and the disinfection of the water stream. Figure 6 illustrates the outcomes of disinfection tests carried out under various inoculation protocols and conditions.

Figure 6.
(a,b) show the disinfection results using the bacteria suspension prepared in PBS, hence in a medium that allows certain bacteria to grow. (c,d) show the disinfection results using the bacteria suspension prepared in diluted LB (by about 107 CFU in PBS), hence in a more favorable medium for bacterial growth. (a,c) show the results of the bacteria counted in the suspension after the treatment. (c,d) show the residual bacteria adsorbed on the material surface. In the photos of both (b,d), there is CS without H2O2 (top-left); CS with 0.2 mM H2O2 (bottom-left); CS functionalized without H2O2 (top-right); CS functionalized with 0.2 mM H2O2 (bottom-right). All the experiments were duplicated.
Figure 6a,b display the results obtained using an inoculation protocol that does not promote bacterial growth (i.e., with a bacterial suspension washed from the culture medium and resuspended in PBS, as outlined in Section 2.8). Figure 6a presents the bacterial concentration in the suspension after 3 h of incubation at 30 °C under various disinfecting conditions. The control test (i.e., the Blank, with bacteria only and no CS material nor added chemical) resulted in 500 CFU, corresponding to the expected initial bacterial inoculum and confirming the protocol’s reliability. No cell proliferation occurred during the 3 h incubation at 30 °C. In tests using either the sole H2O2 at 0.2 mM (H2O2) or the dissolved catalyst at 0.1 mM alone (Cat), neither condition displayed significant biocidal activity within the tested period. However, when both the catalyst and H2O2 were combined in the bacterial suspension, a marked disinfection effect (about 1-log removal) was observed. This suggests that the catalyst effectively generates ROS from H2O2, as corroborated by EPR data, and that these ROS exhibit bactericidal activity under the herein conditions.
In Figure 6b, the materials’ bacteriostatic capabilities, with and without H2O2, were evaluated. After 3 h of contact, a soft agar solution was poured over the material (Section 2.8). This soft agar environment encourages oxygen diffusion and hence bacterial growth if any adsorbed bacteria remained viable and cultivable, as well as their mobility, making bacterial colonies visible upon growth. In all cases (CS and functionalized CS with or without H2O2), no significant bacterial growth was detected, confirming the bacteriostatic properties of the materials in the tested conditions.
All tested materials, including CS and functionalized CS, demonstrated clear disinfection capability with and without H2O2 (Figure 6). The most effective results were achieved with the combination of CS and H2O2, likely due to a synergistic effect between the two in the disinfection process. Interestingly, functionalized CS showed similar disinfection activity both with and without H2O2, making it challenging to determine whether the disinfection is due to ROS generation or simply to residual accessible pure CS present on the material’s surface.
Conversely, Figure 6c,d show results from a protocol designed to encourage bacterial growth by directly immersing the target matrices within a bacterial suspension containing nutrient residues from diluted LB (in PB). This approach mimics a scenario with bacteria that can proliferate, offering insights into the disinfection performance under more challenging conditions where the bacterial population is actively supported. The comparison between these protocols aims to highlight the versatility and effectiveness of disinfection materials across different types of contamination, providing valuable information on their efficiency in real-world water purification applications. Figure 6c refers to the residual bacteria quantity in suspension after 3 h of contact with the materials. As expected, the Blank test with bacteria alone showed a significant increase in bacterial quantity, rising to over 3500 CFU after incubation (Figure 6c), as opposed to 500 CFU in the previous case (Figure 6a). It confirms the protocol’s hypothesis and supports the experimental approach. Solutions in contact with pure CS and the CS + H2O2 combination achieved similar disinfection efficiencies, highlighting the highest contribution of CS compared to H2O2 when employed with higher bacteria load. Indeed, while in Figure 6a, the contribution of H2O2 increases the disinfection efficiency, in Figure 6c, its contribution was not effective, corroborating the low activity of H2O2 detected in Figure 6a. Thus, H2O2 exerts significant synergic activity only at low concentrations of bacteria.
These tests, conducted under higher bacterial concentrations, also helped clarify the mode of action of functionalized CS. Specifically, functionalized CS without H2O2 left a high residual bacterial count (over 3500 CFU) in solution, whereas functionalized CS with H2O2 achieved effective disinfection (see Figure 6c). These findings suggest that functionalized CS requires H2O2 to produce ROS for effective disinfection. Figure 6d reinforces this, showing extensive bacterial growth on the agar surface after incubation with functionalized CS, both with and without H2O2. An explanation could be that ROS are generated and depleted rapidly (as observed through EPR) in a reaction system exposed to quick bacterial growth. Consequently, in harsher conditions (Figure 6d), remaining bacteria can proliferate in the agar during incubation and colonize the material surface, preventing ROS from being further generated and surface CS from being accessible. This confirms that functionalized CS does not achieve disinfection solely through contact but relies on ROS generation and requires the continuous addition of H2O2.
In contrast, pure CS consistently achieved strong disinfection with or without H2O2 when bacteria were able to grow (Figure 6d), potentially due to the slight dissolution of CS (as shown in Figure S3), which enhanced its disinfection efficacy. These findings highlight the versatile applicability of functionalized CS in water purification when combined with H2O2 for effective ROS generation and underscore the strong disinfection capabilities of CS films for water treatment.
3.7. Discussion About the Mode of Disinfection
CS at pH 6 can act in the same fashion as a quaternary ammonium salt (QAS) since the amine group will be protonated due to its pKa in the order of 9 [24]. A QAS is well known in the literature as an effective biocide [47,48]. The positively charged quaternary ammonium ions are attracted to the negatively charged cell materials of bacteria [47,49]. This attraction helps QAS molecules attach firmly to the microbial surface. Once bound to the cell membrane, QAS molecules disrupt the lipid bilayer, causing increased membrane permeability. This destabilizes the cell membrane, leading to leakage of vital cellular contents such as potassium ions, proteins, and nucleotides [50,51]. By interacting with membrane-bound proteins and enzymes, QAS can cause protein denaturation and inhibit key enzymes, disrupting essential cellular processes such as energy production and nutrient transport [50,51]. As the membrane integrity continues to degrade, intracellular contents leak out, leading to cell lysis and, ultimately, cell death. H2O2 can act in a synergic effect with the QAS-like action of CS. Since cell integrity is no longer maintained due to membrane disruption caused by CS, H2O2 may penetrate the cell and oxidize its intracellular components. The generated oxidative stress is highly toxic to the cell and threatens its survival. In addition, Fenton reactions may occur after ferritin denaturation (iron-storage protein), releasing large amounts of iron ions, therefore generating additional ROS [50,52]. The peroxidase enzyme, in charge of cell detoxification, may also be overwhelmed and/or denaturized due to such significant oxidative stress. The simultaneous action of QAS and H2O2 increases the efficiency of disinfection. On the other hand, the functionalized CS shows an ability to generate ROS; hence, the disinfection mode is likely to involve both the direct disruption of the cell membranes and the oxidative denaturation of proteins, including vital enzymes [50,51,52]. Figure 7 reports a scheme of the modes of action of disinfection described above.

Figure 7.
The figure represents a scheme of the possible synergic phenomena involved during the disinfection promoted by CS and CS + H2O2. Thus, it represents the hypothesized action mode of the CS film alone and in cooperation with H2O2. This scheme also depicts the detrimental effects of ROS, as hydroxyl radicals generated by functionalized CS, and how they can affect cellular functions.
4. Conclusions
In this study, we have demonstrated the potential of CS and functionalized CS films as effective materials for water purification applications, particularly in contaminant degradation and bacterial disinfection. The study developed a reproducible preparation protocol for stable CS-based materials as verified by a comprehensive material characterization, including FTIR-ATR, TGA, contact angle, SEM-EDX, mechanical, and permeability tests. These tests reported an improved thermal and water stability of the functionalized CS, indicating increased durability and suitability for water treatments.
The functionalized CS materials demonstrated an activity toward PhOH, attributed to the generation of ROS. EPR analysis confirmed hydroxyl radicals as the primary active species in this catalytic reaction. However, ROS generation was limited, most likely due to self-scavenging phenomena.
In disinfection tests, both pure and functionalized CS materials were effective in reducing bacterial concentration, with pure CS achieving high disinfection performance even under high bacterial load. This efficiency is likely due to the protonated amine groups in CS, which function similarly to QAS, disrupting bacterial cell membranes. Furthermore, the study highlights the potential synergy between pure CS and H2O2, which enhances disinfection at low bacterial concentrations. However, under higher bacterial concentrations, the contribution of H2O2 is less pronounced, underscoring the robustness of CS-based materials in more demanding conditions, without the need for additional oxidants.
The results indicate that the functionalized CS alone does not disinfect by simple contact; rather, it requires H2O2 to generate ROS, effectively inactivating bacteria in highly contaminated environments. This ROS-driven mechanism aligns with EPR observations, confirming that functionalized CS can serve as a catalytic surface for ROS production when coupled with H2O2. However, under low bacterial loads, residual accessible pure CS within the functionalized material may contribute to direct disinfection, broadening its applicability in varying contamination levels.
Overall, these findings support the feasibility of CS and functionalized CS materials for sustainable water purification applications. These characteristics suggest that CS-based materials could be optimized and scaled for practical applications aimed at ensuring safe, contaminant-free water. Future work may focus on refining the catalyst structure to further enhance ROS production and exploring long-term stability and performance in real-world water treatment scenarios.
Supplementary Materials
The following supporting information can be downloaded at: https://www.mdpi.com/article/10.3390/w17213077/s1, Figure S1. Molecular structures of the iron-based catalyst: (a) the catalytic core; (b) the catalytic core functionalized with an acrylamide functional group; Figure S2. UV-Vis spectrum of the catalyst with the acrylamide group concentration, solvent, optical length (see Figure S1b). The broad absorption between 400 and 550 nm corresponds to t2g(FeII)-to-π*(phen), thus specifically reflecting amine-iron bonding. The red line represents the catalyst spectrum prior to immersion of the 3% CS film, while the orange line shows the residual catalyst spectrum in solution after CS functionalization. The quantity of catalyst functionalized onto the material was calculated by measuring the absorbance difference and correlating it to concentration using the Lambert-Beer law, following calibration; Figure S3. Water solubility of (a) 2.5 cm2 of a film of CS 3% in 100 mL of DI water and (b) 2.5 cm2 of a film of CS 3% cat. in 100 mL of DI water. The functionalized CS film resulted perfectly stable in DI water over 1h. The molecular structure in (b) represents the catalyst functionalized on CS surface. The peak at 280 nm is the representative peak of CS; Figure S4. (a) FT-IR of [(Phen)2(Phen-5-yl-acrylamide)FeII](PF6)2 in Transmittance %. (b) TGA of [(Phen)2(Phen-5-yl-acrylamide)FeII](PF6)2. The mass loss occurs above 300 °C, confirming the absence of solvents, and is ascribed to the decomposition of the ligands and counterions. The online version contains supplementary material.
Author Contributions
G.F.: conceptualization, visualization, methodology, investigation, data curation, writing—original draft, project administration, funding acquisition; H.B.: investigation, data curation, writing—editing; F.L.: methodology, data curation; K.S.-D.: methodology, data curation; J.-N.R.: investigation, data curation, visualization; F.B.: visualization; L.S.: conceptualization, supervision, methodology, writing—review and editing; D.Q.: visualization, supervision, writing—review and editing, project administration, funding acquisition. All authors have read and agreed to the published version of the manuscript.
Funding
EU HORIZON-MSCA-2021-PF-01 program (Grant Agreement 101061559).
Data Availability Statement
The original contributions presented in this study are included in the article/supplementary material. Further inquiries can be directed to the corresponding authors.
Acknowledgments
GF acknowledges the University of Montpellier and the support from the project “S-FOX”, funded by the EU HORIZON-MSCA-2021-PF-01 program. Angel Taranto is thanked for his technical support in microbiological assays.
Conflicts of Interest
The authors declare no conflict of interest.
References
- Salehi, M. Global Water Shortage and Potable Water Safety; Today’s Concern and Tomorrow’s Crisis. Environ. Int. 2022, 158, 106936. [Google Scholar] [CrossRef] [PubMed]
- Warren-Vega, W.M.; Campos-Rodríguez, A.; Zárate-Guzmán, A.I.; Romero-Cano, L.A. A Current Review of Water Pollutants in American Continent: Trends and Perspectives in Detection, Health Risks, and Treatment Technologies. Int. J. Environ. Res. Public Health 2023, 20, 4499. [Google Scholar] [CrossRef] [PubMed]
- Khetan, S.K.; Collins, T.J. Human Pharmaceuticals in the Aquatic Environment: A Challenge to Green Chemisty. Chem. Rev. 2007, 107, 2319–2364. [Google Scholar] [CrossRef]
- Vandermeersch, G.; Lourenço, H.M.; Alvarez-Muñoz, D.; Cunha, S.; Diogène, J.; Cano-Sancho, G.; Sloth, J.J.; Kwadijk, C.; Barcelo, D.; Allegaert, W.; et al. Environmental Contaminants of Emerging Concern in Seafood—European Database on Contaminant Levels. Environ. Res. 2015, 143, 29–45. [Google Scholar] [CrossRef]
- Tian, N.; Giannakis, S.; Oji-Okoro, O.C.; Farinelli, G.; Garcia-Muñoz, P.; Pulgarin, C. Photo-Fenton Inactivation of MS2 Bacteriophage at Alkaline PH by Fe Salts or Nm to Μm-Sized Oxides, and the Janus-Faced Effects of Natural Organic Matter in Surface Waters. Catal. Today 2024, 430, 114536. [Google Scholar] [CrossRef]
- Some, S.; Mondal, R.; Mitra, D.; Jain, D.; Verma, D.; Das, S. Microbial Pollution of Water with Special Reference to Coliform Bacteria and Their Nexus with Environment. Energy Nexus 2021, 1, 100008. [Google Scholar] [CrossRef]
- Rizzo, L.; Malato, S.; Antakyali, D.; Beretsou, V.G.; Đolić, M.B.; Gernjak, W.; Heath, E.; Ivancev-Tumbas, I.; Karaolia, P.; Lado Ribeiro, A.R.; et al. Consolidated vs New Advanced Treatment Methods for the Removal of Contaminants of Emerging Concern from Urban Wastewater. Sci. Total Environ. 2019, 655, 986–1008. [Google Scholar] [CrossRef]
- Saravanan, A.; Deivayanai, V.C.; Kumar, P.S.; Rangasamy, G.; Hemavathy, R.V.; Harshana, T.; Gayathri, N.; Alagumalai, K. A Detailed Review on Advanced Oxidation Process in Treatment of Wastewater: Mechanism, Challenges and Future Outlook. Chemosphere 2022, 308, 136524. [Google Scholar] [CrossRef]
- Priyadarshini, M.; Das, I.; Ghangrekar, M.M.; Blaney, L. Advanced Oxidation Processes: Performance, Advantages, and Scale-up of Emerging Technologies. J. Environ. Manag. 2022, 316, 115295. [Google Scholar] [CrossRef]
- Ma, D.; Yi, H.; Lai, C.; Liu, X.; Huo, X.; An, Z.; Li, L.; Fu, Y.; Li, B.; Zhang, M.; et al. Critical Review of Advanced Oxidation Processes in Organic Wastewater Treatment. Chemosphere 2021, 275, 130104. [Google Scholar] [CrossRef] [PubMed]
- Coha, M.; Farinelli, G.; Tiraferri, A.; Minella, M.; Vione, D. Advanced Oxidation Processes in the Removal of Organic Substances from Produced Water: Potential, Configurations, and Research Needs. Chem. Eng. J. 2021, 414, 128668. [Google Scholar] [CrossRef]
- Giwa, A.; Yusuf, A.; Balogun, H.A.; Sambudi, N.S.; Bilad, M.R.; Adeyemi, I.; Chakraborty, S.; Curcio, S. Recent Advances in Advanced Oxidation Processes for Removal of Contaminants from Water: A Comprehensive Review. Process Saf. Environ. Prot. 2021, 146, 220–256. [Google Scholar] [CrossRef]
- Giannakis, S.; Gamarra Vives, F.A.; Grandjean, D.; Magnet, A.; De Alencastro, L.F.; Pulgarin, C. Effect of Advanced Oxidation Processes on the Micropollutants and the Effluent Organic Matter Contained in Municipal Wastewater Previously Treated by Three Different Secondary Methods. Water Res. 2015, 84, 295–306. [Google Scholar] [CrossRef]
- Chen, Y.; Duan, X.; Zhou, X.; Wang, R.; Wang, S.; Ren, N.; Ho, S.-H. Advanced Oxidation Processes for Water Disinfection: Features, Mechanisms and Prospects. Chem. Eng. J. 2021, 409, 128207. [Google Scholar] [CrossRef]
- Merchant, A.I.; Vakili, A.H.; KOCAMAN, A.; Abu Amr, S.S. New Advancement of Advanced Oxidation Processes for the Treatment of Petroleum Wastewater. Desalin. Water Treat. 2024, 319, 100565. [Google Scholar] [CrossRef]
- Arzate, S.; Pfister, S.; Oberschelp, C.; Sánchez-Pérez, J.A. Environmental Impacts of an Advanced Oxidation Process as Tertiary Treatment in a Wastewater Treatment Plant. Sci. Total Environ. 2019, 694, 133572. [Google Scholar] [CrossRef]
- Xu, J.; McCarthy, S.P.; Gross, R.A.; Kaplan, D.L. Chitosan Film Acylation and Effects on Biodegradability. Macromolecules 1996, 29, 3436–3440. [Google Scholar] [CrossRef]
- Bagheri-Khoulenjani, S.; Taghizadeh, S.M.; Mirzadeh, H. An Investigation on the Short-Term Biodegradability of Chitosan with Various Molecular Weights and Degrees of Deacetylation. Carbohydr. Polym. 2009, 78, 773–778. [Google Scholar] [CrossRef]
- Peramune, D.; Manatunga, D.C.; Dassanayake, R.S.; Premalal, V.; Liyanage, R.N.; Gunathilake, C.; Abidi, N. Recent Advances in Biopolymer-Based Advanced Oxidation Processes for Dye Removal Applications: A Review. Environ. Res. 2022, 215, 114242. [Google Scholar] [CrossRef] [PubMed]
- Lin, K.-Y.A.; Lin, J.-T.; Yang, H. Ferrocene-Modified Chitosan as an Efficient and Green Heterogeneous Catalyst for Sulfate-Radical-Based Advanced Oxidation Process. Carbohydr. Polym. 2017, 173, 412–421. [Google Scholar] [CrossRef]
- Yadav, M.; Goswami, P.; Paritosh, K.; Kumar, M.; Pareek, N.; Vivekanand, V. Seafood Waste: A Source for Preparation of Commercially Employable Chitin/Chitosan Materials. Bioresour. Bioprocess. 2019, 6, 8. [Google Scholar] [CrossRef]
- Zuo, Y.; Zhan, J.; Costa, N. Use of Shell Chitin Extracted from Seafood Processing Waste in Recycling of Industrial Wastewater. In Proceedings of the Environmentally Conscious Manufacturing, Boston, MA, USA, 9 February 2001; Volume 4193, pp. 403–412. [Google Scholar]
- Ke, C.-L.; Deng, F.-S.; Chuang, C.-Y.; Lin, C.-H. Antimicrobial Actions and Applications of Chitosan. Polymers 2021, 13, 904. [Google Scholar] [CrossRef]
- Rabea, E.I.; Badawy, M.E.-T.; Stevens, C.V.; Smagghe, G.; Steurbaut, W. Chitosan as Antimicrobial Agent: Applications and Mode of Action. Biomacromolecules 2003, 4, 1457–1465. [Google Scholar] [CrossRef] [PubMed]
- Hussein, M.H.M.; El-Hady, M.F.; Sayed, W.M.; Hefni, H. Preparation of Some Chitosan Heavy Metal Complexes and Study of Its Properties. Polym. Sci. Ser. A 2012, 54, 113–124. [Google Scholar] [CrossRef]
- Guibal, E. Heterogeneous Catalysis on Chitosan-Based Materials: A Review. Prog. Polym. Sci. 2005, 30, 71–109. [Google Scholar] [CrossRef]
- Rashid, S.; Shen, C.; Chen, X.; Li, S.; Chen, Y.; Wen, Y.; Liu, J. Enhanced Catalytic Ability of Chitosan–Cu–Fe Bimetal Complex for the Removal of Dyes in Aqueous Solution. RSC Adv. 2015, 5, 90731–90741. [Google Scholar] [CrossRef]
- Farinelli, G.; Di Luca, A.; Kaila, V.R.I.; MacLachlan, M.J.; Tiraferri, A. Fe-Chitosan Complexes for Oxidative Degradation of Emerging Contaminants in Water: Structure, Activity, and Reaction Mechanism. J. Hazard. Mater. 2021, 408, 124662. [Google Scholar] [CrossRef]
- Lee, M.; Chen, B.-Y.; Den, W. Chitosan as a Natural Polymer for Heterogeneous Catalysts Support: A Short Review on Its Applications. Appl. Sci. 2015, 5, 1272–1283. [Google Scholar] [CrossRef]
- Guibal, E.; Vincent, T.; Navarro, R. Metal Ion Biosorption on Chitosan for the Synthesis of Advanced Materials. J. Mater. Sci. 2014, 49, 5505–5518. [Google Scholar] [CrossRef]
- Al Momani, D.E.; Arshad, F.; Zou, L. Chitosan/MoS2/GO Membrane for Catalytic Degradation of Organic Contaminants. Environ. Technol. Innov. 2023, 32, 103410. [Google Scholar] [CrossRef]
- Gonçalves, J.O.; de Farias, B.S.; Rios, E.C.; Jaeschke, D.P.; Ribeiro, A.C.; da Silva, M.D.; Vieira, M.L.G.; Carvalho, V.V.d.L.; Cadaval, T.R.S.; Pinto, L.A.d.A. Advances in Chitosan-Based Materials for Application in Catalysis and Adsorption of Emerging Contaminants. Sustainability 2024, 16, 8321. [Google Scholar] [CrossRef]
- Ostrowska-Czubenko, J.; Gierszewska-Drużyńska, M. Effect of Ionic Crosslinking on the Water State in Hydrogel Chitosan Membranes. Carbohydr. Polym. 2009, 77, 590–598. [Google Scholar] [CrossRef]
- Ostrowska-Czubenko, J.; Pieróg, M.; Gierszewska-Drużyńska, M. Water State in Chemically and Physically Crosslinked Chitosan Membranes. J. Appl. Polym. Sci. 2013, 130, 1707–1715. [Google Scholar] [CrossRef]
- Farinelli, G.; Minella, M.; Pazzi, M.; Giannakis, S.; Pulgarin, C.; Vione, D.; Tiraferri, A. Natural Iron Ligands Promote a Metal-Based Oxidation Mechanism for the Fenton Reaction in Water Environments. J. Hazard. Mater. 2020, 393, 122413. [Google Scholar] [CrossRef]
- Papoutsakis, S.; Brites-Nóbrega, F.F.; Pulgarin, C.; Malato, S. Benefits and Limitations of Using Fe(III)-EDDS for the Treatment of Highly Contaminated Water at near-Neutral PH. J. Photochem. Photobiol. A Chem. 2015, 303–304, 1–7. [Google Scholar] [CrossRef]
- Pirkin-Benameur, J.; Bouad, V.; Lefèbvre, F.; Bouyer, D.; Sénéchal-David, K.; Rebilly, J.-N.; Banse, F.; Fournier, D.; Woisel, P.; Lyskawa, J.; et al. Revitalizing Inert Materials: Grafting Self-Oscillating, Stimuli-Responsive Organometallic Polymers for Pulsating Systems. Adv. Mater. Interfaces 2023, 10, 2300346. [Google Scholar] [CrossRef]
- Farinelli, G.; Rebilly, J.-N.; Banse, F.; Cretin, M.; Quemener, D. Assessment of New Hydrogen Peroxide Activators in Water and Comparison of Their Active Species toward Contaminants of Emerging Concern. Sci. Rep. 2024, 14, 9301. [Google Scholar] [CrossRef]
- Tartanson, M.A.; Soussan, L.; Rivallin, M.; Chis, C.; Penaranda, D.; Lapergue, R.; Calmels, P.; Faur, C. A New Silver Based Composite Material for SPA Water Disinfection. Water Res. 2014, 63, 135–146. [Google Scholar] [CrossRef]
- Quadrado, R.F.N.; Macagnan, K.L.; Moreira, A.S.; Fajardo, A.R. Chitosan-Based Hydrogel Crosslinked through an Aza-Michael Addition Catalyzed by Boric Acid. Int. J. Biol. Macromol. 2021, 193, 1032–1042. [Google Scholar] [CrossRef]
- Rajabi, M.; Cabral, J.; Saunderson, S.; Ali, M.A. Green Synthesis of Chitooligosaccharide-PEGDA Derivatives through Aza-Michael Reaction for Biomedical Applications. Carbohydr. Polym. 2022, 295, 119884. [Google Scholar] [CrossRef]
- Pawlak, A.; Mucha, M. Thermogravimetric and FTIR Studies of Chitosan Blends. Thermochim. Acta 2003, 396, 153–166. [Google Scholar] [CrossRef]
- Fernandes Queiroz, M.; Melo, K.; Sabry, D.; Sassaki, G.; Rocha, H. Does the Use of Chitosan Contribute to Oxalate Kidney Stone Formation? Mar. Drugs 2014, 13, 141–158. [Google Scholar] [CrossRef]
- Liu, F.; Liu, Y.; Guo, Y.; Liu, J.; Dong, J.; Wang, T.; Hao, D.; Zhang, Y. FTIR Determination of the Degree of Molar Substitution for Hydroxypropyl Chitosan. Carbohydr. Polym. 2024, 339, 122229. [Google Scholar] [CrossRef] [PubMed]
- Farinelli, G.; Minella, M.; Sordello, F.; Vione, D.; Tiraferri, A. Metabisulfite as an Unconventional Reagent for Green Oxidation of Emerging Contaminants Using an Iron-Based Catalyst. ACS Omega 2019, 4, 20732–20741. [Google Scholar] [CrossRef] [PubMed]
- Buettner, G.R. Spin Trapping: ESR Parameters of Spin Adducts 1474 1528V. Free Radic. Biol. Med. 1987, 3, 259–303. [Google Scholar] [CrossRef]
- Zhou, Z.; Zhou, S.; Zhang, X.; Zeng, S.; Xu, Y.; Nie, W.; Zhou, Y.; Xu, T.; Chen, P. Quaternary Ammonium Salts: Insights into Synthesis and New Directions in Antibacterial Applications. Bioconjug. Chem. 2023, 34, 302–325. [Google Scholar] [CrossRef]
- Kwaśniewska, D.; Chen, Y.-L.; Wieczorek, D. Biological Activity of Quaternary Ammonium Salts and Their Derivatives. Pathogens 2020, 9, 459. [Google Scholar] [CrossRef]
- Han, Y.; Zhou, Z.-C.; Zhu, L.; Wei, Y.-Y.; Feng, W.-Q.; Xu, L.; Liu, Y.; Lin, Z.-J.; Shuai, X.-Y.; Zhang, Z.-J.; et al. The Impact and Mechanism of Quaternary Ammonium Compounds on the Transmission of Antibiotic Resistance Genes. Environ. Sci. Pollut. Res. 2019, 26, 28352–28360. [Google Scholar] [CrossRef]
- Giannakis, S.; López, M.I.P.; Spuhler, D.; Pérez, J.A.S.; Ibáñez, P.F.; Pulgarin, C. Solar Disinfection Is an Augmentable, in Situ-Generated Photo-Fenton Reaction—Part 2: A Review of the Applications for Drinking Water and Wastewater Disinfection. Appl. Catal. B Environ. 2016, 198, 431–446. [Google Scholar] [CrossRef]
- Giannakis, S.; Polo López, M.I.; Spuhler, D.; Sánchez Pérez, J.A.; Fernández Ibáñez, P.; Pulgarin, C. Solar Disinfection Is an Augmentable, in Situ -Generated Photo-Fenton Reaction—Part 1: A Review of the Mechanisms and the Fundamental Aspects of the Process. Appl. Catal. B Environ. 2016, 199, 199–223. [Google Scholar] [CrossRef]
- Farinelli, G.; Giagnorio, M.; Ricceri, F.; Giannakis, S.; Tiraferri, A. Evaluation of the Effectiveness, Safety, and Feasibility of 9 Potential Biocides to Disinfect Acidic Landfill Leachate from Algae and Bacteria. Water Res. 2021, 191, 116801. [Google Scholar] [CrossRef] [PubMed]
Disclaimer/Publisher’s Note: The statements, opinions and data contained in all publications are solely those of the individual author(s) and contributor(s) and not of MDPI and/or the editor(s). MDPI and/or the editor(s) disclaim responsibility for any injury to people or property resulting from any ideas, methods, instructions or products referred to in the content. |
© 2025 by the authors. Licensee MDPI, Basel, Switzerland. This article is an open access article distributed under the terms and conditions of the Creative Commons Attribution (CC BY) license (https://creativecommons.org/licenses/by/4.0/).










